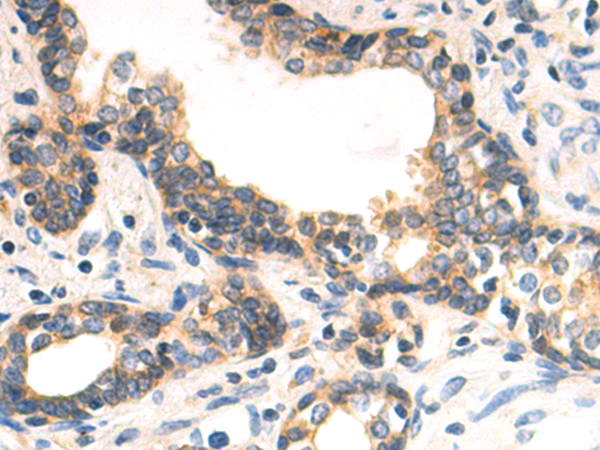

-
分类: 科研抗体货号: P09984别名: AC19; RPA9; TCS2; RPA16; RPAC2; RPC16; POLR1C; RPO1-3应用: IHC反应种属: Human
-
分类: 科研抗体货号: P10017别名: H2B/d; H2BFD; HIST1H2BN应用: WB,IHC反应种属: Human, Mouse
-
分类: 科研抗体货号: P10002别名: PZR; PZRa; PZRb; PZR1b; MPZL1b应用: IHC反应种属: Human, Mouse, Rat
-
分类: 科研抗体货号: P09983别名: ARPP-19e应用: IHC反应种属: Human, Mouse, Rat
-
分类: 科研抗体货号: P10016别名: FAT10; UBD-3; GABBR1应用: IHC反应种属: Human
-
分类: 科研抗体货号: P10001别名: HBE应用: WB,IHC反应种属: Human
-
分类: 科研抗体货号: P09982别名: SMD1; SNRPD; Sm-D1; HsT2456应用: IHC反应种属: Human, Mouse
-
分类: 科研抗体货号: P10015别名: BART; RP66; BART1应用: WB,IHC反应种属: Human, Mouse, Rat
-
分类: 科研抗体货号: P10000别名:应用: IHC反应种属: Human, Mouse, Rat
-
分类: 科研抗体货号: P10013别名: MNK2; GPRK7应用: WB,IHC反应种属: Human, Mouse, Rat

鄂公网安备42018502007531号
鄂公网安备42018502007531号

